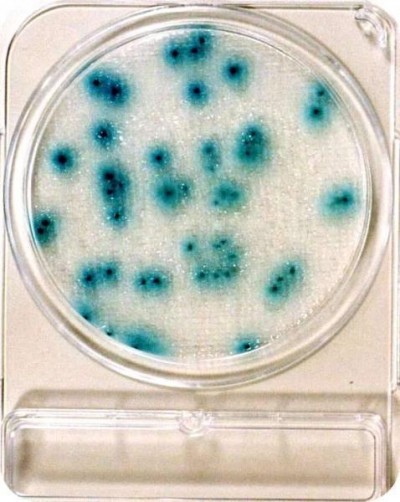

Compact Dry YM
Pret: neprecizat
Producator: Japonia
Produs publicat de: ATC INVESTMENT -- Iasi (Iasi) , telefon: 0744620271 / 0744620271
Producator: Japonia
Produs publicat de: ATC INVESTMENT -- Iasi (Iasi) , telefon: 0744620271 / 0744620271
Mediu de cultura turnat pe placa, in forma deshidratata. Se utilizeaza la detectia si numararea drojdiilor si mucegaiurilor din mostre de mediu (teste de sanitatie), alimentare sau medicale. Standard ISO 16150:2004.
Mediu de cultura turnat pe placa, in forma deshidratata. Se utilizeaza la detectia si numararea drojdiilor si mucegaiurilor din mostre de mediu (teste de sanitatie), alimentare sau medicale. Standard ISO 16150:2004.
Solicitare informații / comandă produs (mesaj către ATC INVESTMENT):
Nr. vizite 2113